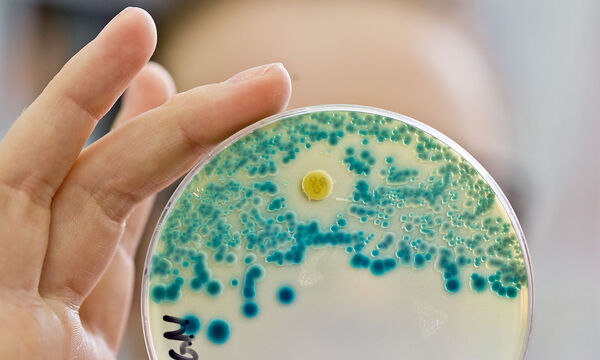
Multiresistente Keime

Von 2020 bis 2021 ist der Einsatz von Breitband-Antibiotika in Krankenhäusern der EU- und EWR-Staaten stark gestiegen. Die ECDC meldet einen „besorgniserregenden Anstieg“ an Todesfällen durch Antibiotika-resistente Keime.
In Europa sterben jedes Jahr rund 35.000 Menschen an Antibiotika-resistenten Bakterien. Der am Donnerstag präsentierte Antibiotika-Bericht der europäischen Seuchenbehörde ECDC zeigt einen Anstieg der Todesfälle gegenüber früheren Schätzungen. "Jeden Tag sterben im EU/EWR-Gebiet fast 100 Menschen an diesen Infektionen", betonte ECDC-Direktorin Andrea Ammon. Die gesundheitlichen Auswirkungen seien vergleichbar mit denen von Influenza, Tuberkulose und HIV/AIDS zusammen.
"Wir sehen einen besorgniserregenden Anstieg der Zahl der Todesfälle, die auf Infektionen mit Antibiotika-resistenten Bakterien zurückzuführen sind, insbesondere solche, die gegen antimikrobielle Mittel der letzten Wahl resistent sind", erläuterte Ammon. In den 2018 und 2019 veröffentlichten ECDC-Berichten war noch von 33.000 Todesopfern ausgegangen worden. Es brauche u.a. mehr Anstrengungen, um den unnötigen Einsatz von Antibiotika weiter zu reduzieren sowie die Praktiken zur Infektionsprävention und -kontrolle zu verbessern, auch auf nationaler Ebene, sagte Ammon.
Einsatz von Breitband-Antibiotika in Spitälern gestiegen
Im Jahr 2021 war die Zahl der gemeldeten Fälle von Acinetobacter-Keimen, die gegen verschiedene Antibiotika resistent sind, mit plus 121 Prozent mehr als doppelt so hoch wie im Durchschnitt der Jahre 2018 bis 2019. Auch der Anstieg der Klebsiella-pneumoniae-Fälle war im Jahr 2020 mit 31 Prozent und im Jahr 2021 mit weiteren 20 Prozent deutlich. Diese Bakterien stellen eine häufige Ursache von Harnwegs-, Atemwegs- und Blutbahninfektionen dar und sind resistent gegen die Antibiotikagruppe der sogenannten Carbapeneme.
Von 2012 bis 2021 wurde in den EU- und EWR-Staaten ein Rückgang des Gesamtverbrauchs antimikrobieller Mittel beim Menschen in der Primärversorgung und im Krankenhaus um 23 Prozent erzielt. Trotz dieses Erfolgs hat laut ECDC im gleichen Zeitraum der Anteil der eingesetzten Breitband-Antibiotika zugenommen, insbesondere in Krankenhäusern um 15 Prozent. Die niedrigsten Prozentsätze von Antibiotika-Resistenzen wurden aus nordeuropäischen Ländern gemeldet, die höchsten im Süden und Osten Europas.